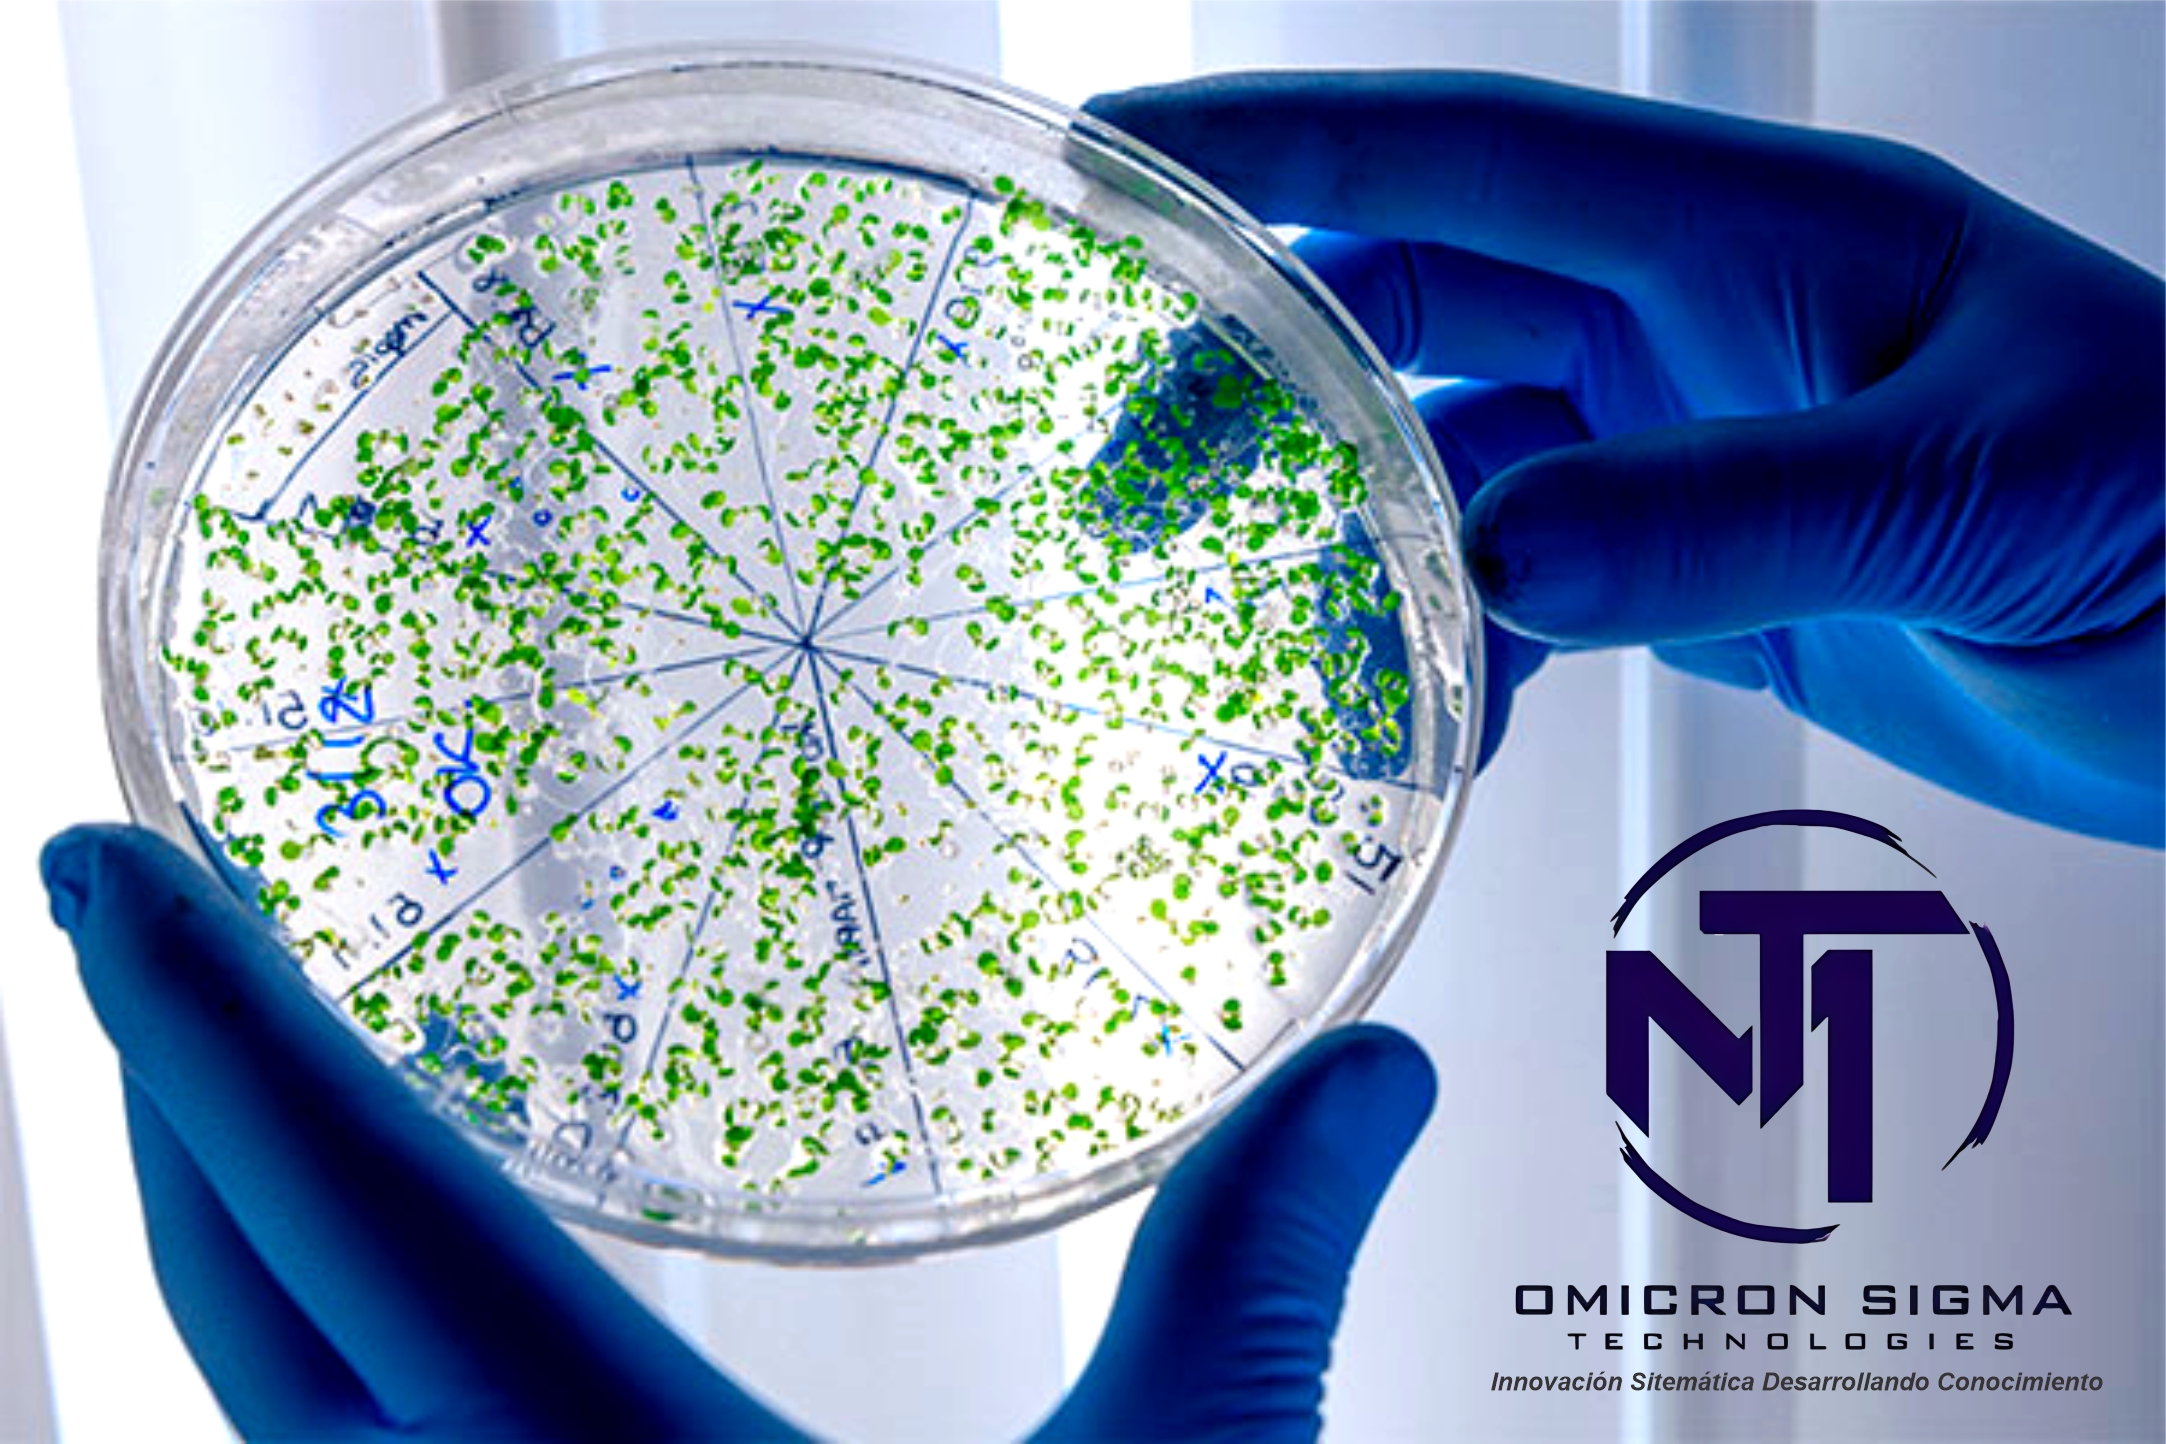
https://0201.nccdn.net/4_2/000/000/01e/20c/cultivo.jpg

MT Ómicron Sigma Technologies es una empresa mexicana, cuyo principal objetivo es el proporcionar al mercado la más avanzada tecnología en control de infecciones y su prevención en las diversas áreas intrahospitalarias, teniendo un profundo respeto por la inocuidad y una contundencia total con la efectividad frente a los principales microorganismos patógenos.
Misión:
Nuestra misión: Ser una empresa mexicana líder comprometida con la innovación, tecnología, desarrollo e investigación de productos desinfectantes y antisépticos de alta calidad. Buscamos brindar soluciones efectivas y seguras para la prevención y control de enfermedades, contribuyendo así a mejorar la salud y el bienestar de las personas en México y en todo el mundo.
Visión:
Nuestra visión: Convertirnos en la empresa referente en México en el campo de la innovación y tecnología aplicada a productos desinfectantes y antisépticos. Queremos ser reconocidos por nuestra excelencia en investigación y desarrollo, así como por la calidad y eficacia de nuestros productos. Aspiramos a expandir nuestra presencia global y ser un actor clave en la lucha contra las enfermedades infecto-contagiosas, aportando soluciones vanguardistas y sostenibles.
Valores:
1. Innovación: Promovemos la creatividad y la búsqueda constante de nuevas soluciones en el desarrollo de nuestros productos desinfectantes y antisépticos. Estamos comprometidos con la mejora continua y la adopción de tecnologías avanzadas para ofrecer soluciones efectivas y eficientes.
2. Calidad: Nos esforzamos por cumplir con los más altos estándares de calidad en todos nuestros productos y procesos. Trabajamos con rigurosidad y dedicación para garantizar que nuestros productos sean seguros, confiables y efectivos en la desinfección y protección contra enfermedades.
3. Sostenibilidad: Nos preocupamos por el impacto ambiental y social de nuestras operaciones. Buscamos desarrollar productos que sean respetuosos con el medio ambiente, promoviendo prácticas de producción y distribución sostenibles. Además, nos comprometemos a apoyar proyectos y comunidades locales, contribuyendo así al desarrollo social y económico de nuestro entorno.
4. Ética: Actuamos con integridad y transparencia en todas nuestras relaciones comerciales y en el cumplimiento de las regulaciones y normativas aplicables. Promovemos un ambiente laboral seguro y respetuoso, donde se valore la diversidad, la igualdad de oportunidades y el trabajo en equipo.
5. Compromiso: Estamos comprometidos con la salud y el bienestar de las personas. Nuestro objetivo es brindar soluciones efectivas que contribuyan a prevenir y controlar enfermedades, protegiendo así la vida y la salud de nuestros clientes y de la comunidad en general. Trabajamos con pasión y determinación para lograr nuestras metas y objetivos, superando los desafíos y ofreciendo resultados excelentes.